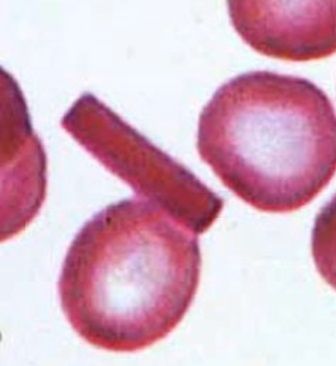

O que é a FlixVet?
Central de informações
A FlixVet é uma central de dicas, curiosidades e informações sobre os pets de fácil compreensão, tudo para você dar a melhor qualidade de vida aos nossos queridos pets!
Conteúdo veterinário
Serão fornecidas diversas revisões de literatura sobre as mais diversas afecções dos pets com atualizações frequentes!
Assim, você, médico veterinário, poderá tirar dúvidas e ficará por dentro dos melhores e dos tratamentos mais atuais!
Combatendo as FakeNews
Não se preocupem: todas as informações postadas nas páginas do site são retiradas de livros e revistas científicas com as referências bibliográficas, evitando assim informações falsas e erradas, as famosas FakeNews!